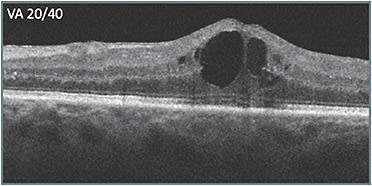
A: Initial OCT

A 54-year-old female presented after having been treated by another physician with approximately 8 treatments for nonproliferative diabetic retinopathy (NPDR) and reduced vision (20/40). Leakage was present on the previously obtained initial ultra-widefield angiography. The previously obtained initial OCT scans (A) showed cystic fluid but intact retinal layer integrity, with the exception of some attenuation of the outer retinal layers, and only 1 noticeable hyperreflective focus nasally. Edema persisted and therapy was switched. After 2 treatments with the second therapy, vision improved slightly to 20/30 and edema improved (B).

Unfortunately, the patient was unable to return for 10 weeks. When she did return, (C) her vision had worsened dramatically (20/150). In deciding what to do, the apparent progression of disease signs that had occurred over time (B & C) were considered. Retinal layer disorganization progressed, including what appeared to be signs of DRIL. More hyperreflective foci appeared as well, presumably indicating accumulation of exudate, including near the fovea. The decision was made to switch to a different class of therapy, which produced a favorable response (D). Vision improved from 20/150 to 20/60, and the retinal anatomy appeared as intact as it had been during the course of treatment.


The patient’s macular edema continues to be active, but with the regimented treatment, her status has been stable. While 20/60 visual acuity (VA) was an improvement, it’s not optimal, which raises the question of whether switching to a different treatment class sooner may have helped prevent progression to retinal layer disruption.








